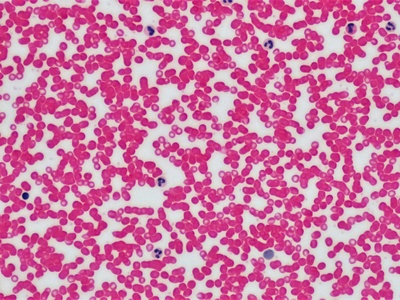
Blood (red blood cells)

Across workshops, labs, and construction sites, suspension systems determine how things absorb shock, control motion, or span gaps. A quick sense of the common types helps whether you’re diagnosing a vehicle, studying materials, or planning a structure.
There are 20 Examples of Suspensions, ranging from 4-3 suspension to Suspension bridge. The list is laid out so you can compare entries at a glance using Category,Typical measure (unit),Where found / used — you’ll find below.
How should I use this list to pick the right suspension type?
Use the Category and Typical measure (unit) columns to match functional needs (load, travel, frequency) and the Where found / used column to see real-world applications; start by identifying the performance requirement, then scan similar examples for scale and context.
Can a single suspension example belong to more than one category?
Yes. Many systems overlap categories depending on design and use — for example, a cable-stayed element might appear under structural and transport-related categories; the table notes primary category and typical measures to keep comparisons practical.
Examples of Suspensions
| Name | Category | Typical measure (unit) | Where found / used |
|---|---|---|---|
| Muddy water | Chemical | particle size 1-100 µm | Rivers, storm drains, construction sites |
| Latex paint | Chemical | particle size 0.1-10 µm | Homes, commercial painting, automotive coatings |
| Blood (red blood cells) | Chemical | particle size 6-8 µm | Hospitals, labs, bodies |
| Fog | Chemical | droplet size 1-20 µm | Outdoor atmosphere, airports, coastal areas |
| Car coil spring | Mechanical | travel 100-200 mm | Passenger cars, SUVs, light trucks |
| MacPherson strut | Mechanical | travel 150 mm | Compact and mid-size cars, front suspension systems |
| Shock absorber (damper) | Mechanical | stroke 50-150 mm | Cars, motorcycles, industrial machinery |
| Bicycle suspension fork | Mechanical | travel 80-160 mm | Mountain bikes, off-road bicycles |
| Air suspension | Mechanical | ride height 50-150 mm adjustable | Luxury cars, buses, trucks, aftermarket systems |
| Leaf spring | Mechanical | travel 150-250 mm | Pickup trucks, vans, commercial vehicles |
| Employee suspension | Legal | duration 1-30 days | Workplaces, HR investigations, corporate discipline |
| Driver’s license suspension | Legal | duration 30-365 days | Traffic courts, licensing agencies, law enforcement |
| Student suspension | Legal | duration 1-10 days | K-12 schools, colleges, university disciplinary systems |
| Amoxicillin oral suspension | Pharmaceutical | concentration 25 mg/mL | Clinics, pediatric prescriptions, pharmacies |
| Pediatric acetaminophen suspension | Pharmaceutical | concentration 32 mg/mL | Homes, pediatric clinics, pharmacies |
| 4-3 suspension | Musical | duration 1 beat | Classical harmony education, choral writing |
| 7-6 suspension | Musical | duration 1 beat | Baroque and classical music, composition exercises |
| Doping suspension | Sports | duration 24 months | Olympics, professional cycling, athletics |
| Red card suspension | Sports | duration 1-3 games | Soccer/football leagues, tournaments |
| Suspension bridge | Structural | span 1,000 m | Long-span crossings, major highway links, coastal inlets |
Images and Descriptions

Muddy water
A common suspension of mineral soil and organic matter in water; visible turbidity makes it notable for sediment transport, water treatment challenges, and construction-site runoff concerns.

Latex paint
Pigment and polymer particles dispersed in water give paint its color and body; it’s notable for stable colloidal behavior, even finish, and considerations like settling, thinning, and shelf life.
Blood (red blood cells)
Red blood cells suspended in plasma form a biological suspension vital for oxygen transport; hematocrit is a key measurable property and affects viscosity, clinical tests, and transfusion handling.

Fog
Tiny liquid water droplets suspended in air reduce visibility and influence weather and transportation; droplet size determines how long fog lingers and how it scatters light.

Car coil spring
A helical metal spring that supports vehicle weight and stores energy from bumps; paired with dampers it controls ride comfort and handling through measurable wheel travel.

MacPherson strut
A space-efficient suspension module combining a shock absorber and coil spring in one unit; widely used for its compactness, predictable geometry, and cost-effectiveness.

Shock absorber (damper)
A hydraulic or gas device that dissipates spring energy by damping motion; stroke and damping force determine ride control and how quickly oscillations settle.

Bicycle suspension fork
A front fork with internal springs and damping that smooths rough terrain; travel and stiffness affect rider control, comfort, and trail performance.

Air suspension
Uses pressurized air bags instead of metal springs to support load and adjust ride height; notable for tunable comfort, leveling under load, and variable ride characteristics.

Leaf spring
Stacked metal leaves that flex to support vehicle loads; durable and simple, commonly used where heavy loads and robust performance are priorities.

Employee suspension
Temporary administrative leave removing an employee from duties during inquiries or as discipline; duration varies by policy and is used to protect investigations or workplace safety.

Driver’s license suspension
A temporary withdrawal of driving privileges for offenses like DUI or excessive points; suspension length depends on severity, prior record, and legal jurisdiction.

Student suspension
Temporary exclusion from classes or campus for behavioral or policy violations; meant as disciplinary response, safety measure, or time for corrective action.

Amoxicillin oral suspension
A reconstituted antibiotic liquid commonly dosed for children; notable for stability after mixing, taste-masking, and concentration that simplifies pediatric dosing calculations.

Pediatric acetaminophen suspension
A liquid formulation of acetaminophen for children (160 mg/5 mL); suspends analgesic particles for accurate dosing, fever reduction, and easier administration to young patients.

4-3 suspension
A voice-leading device where a chord tone is held then resolves down by step; the 4-3 suspension is a fundamental expressive tension-and-release technique in tonal music.

7-6 suspension
A dissonant tone prepared and then resolved upward or downward by a step; the 7-6 suspension is a common cadential ornament that creates expressive harmonic delay.

Doping suspension
A formal ban imposed for use of prohibited performance-enhancing substances; suspension length varies by rulebook and can cost athletes titles, earnings, and career time.

Red card suspension
Automatic match bans following a sending-off offense; short suspensions remove players for subsequent fixtures and impact team selection and competitive outcomes.

Suspension bridge
A bridge type where the deck hangs from cables draped over towers; notable for enabling the longest spans, iconic engineering aesthetics, and efficient load distribution.



